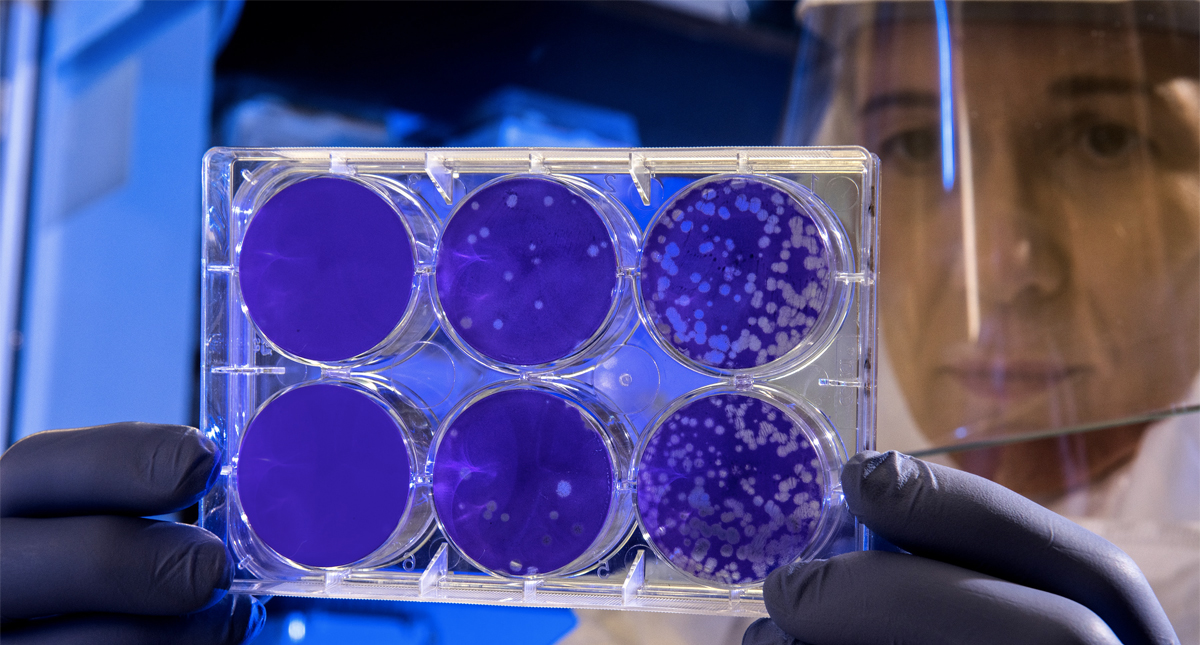
OMS convoca a reunión de emergencia por nuevo brote de virus en China

Este martes se confirmó el primer caso de coronavirus en Estados Unidos donde una persona se mantiene "bastante enferma" tras viajar a Wuhan Leer más
Minuto a Minuto
Deportes Grupo J Mundial 2026: Argentina con paso perfecto y empate de locura entre Argelia y Austria
Argentina confirmó su condición de favorito ante Jordania, mientras que Argelia y Austria protagonizaron un empate electrizante
Deportes Mundial 2026: República Democrática del Congo consigue histórica clasificación a 16vos
La República Democrática del Congo remontó a Uzbekistán para conseguir su histórica clasificación a 16vos del Mundial 2026
Deportes Alejandro Mejía, del equipo Caliente de Durango, gana el Home Run Derby 2026 de la LMB
Aparte de representar con orgullo a la novena que debutó en LMB en 2024, rompió récord de mayor cantidad de HR en una ronda del certamen
Internacional Alto el fuego se tambalea: EE.UU. lanza nueva ofensiva contra Irán
Estuvo dirigida contra infraestructura de vigilancia militar, comunicaciones, defensa aérea, almacenamiento de drones y minas navales
Deportes ¡Inician los 16vos de final del Mundial 2026! ¿A qué hora y dónde ver el Sudáfrica vs Canadá hoy domingo 28 de junio?
Sudáfrica y Canadá abren los 16vos de final en la Copa Mundial de la FIFA 2026 la tarde de este domingo 28 de junio
coronavirus
Autoridades sanitarias de China confirmaron que el nuevo coronavirus conocido como 'neumonía de Wuhan' se contagia por contacto humano Leer más
Hasta el momento, también se han confirmado dos casos de pacientes contagiados en Tailandia, uno en Japón y otro en Corea del Sur Leer más
La OMS celebrará en Ginebra una reunión de expertos para determinar si el actual brote por coronavirus en China constituye una emergencia internacional Leer más
La víctima mortal se trata de un hombre de 69 años que murió este jueves en Wuhan, capital de la provincia Hubei, en China Leer más
Podría pasar un rato largo dando cifras, de esas que se nublan cuando hablamos de cambiar nuestros hábitos, porque nos cuesta dejar la vida que llevamos Leer más
En China se registraron más de 40 casos de un nuevo coronavirus que ya provocaron una muerte, por lo que la OMS activó medidas de prevención Leer más
En la actualidad solo hay 4 pacientes en condición inestable por el coronavirus, y 258 personas en cuarentena ante posibles síntomas. Leer más
Sin embargo, de este total 54 personas ya fueron dadas de alta luego de recuperarse completamente de este mortal coronavirus. Leer más
El paciente del coronavirus es un hombre de 75 años de edad oriundo de Omán y que viajó a Bangkok para tratarse una condición cardiaca. Leer más
Ahora ya son siete víctimas mortales por el coronavirus y el gobierno ha anunciado un plan para poder erradicar el virus esta misma semana Leer más
En todo el país hay mil 600 personas en cuarentena y cerca de 700 escuelas cerraron temporalmente para mitigar los contagios por MERS. Leer más